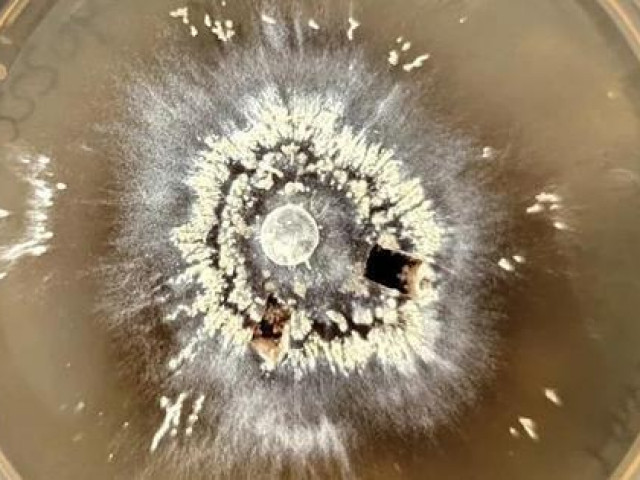
Công nghệ thông tin - Dàn sinh vật hồi sinh trong hỏa ngục ngay trên Trái Đất

Sốc: Sự sống trên Trái đất đến từ tiểu hành tinh cách đây 3,8 tỷ năm, NASA có bằng chứng?
Các nhà khoa học NASA cùng với các nhà nghiên cứu từ Nhật Bản đã tìm ra mối liên hệ quan trọng giữa sự sống trên Trái đất với các tiểu hành tinh trong khi nghiên cứu các thành phần của DNA và RNA, theo Hindustan Times.
NASA cho biết, luôn có một câu hỏi thường trực trong tâm trí các nhà khoa học rằng, cuộc sống trên Trái đất bắt đầu như thế nào?
Câu hỏi muôn thuở này vốn có vô số giả thiết và câu trả lời khác nhau. Một trong số đó là giả thiết sự sống trên Trái đất trên thực tế có thể đến từ một tiểu hành tinh ngoài vũ trụ.
Giả thiết này được củng cố khi các nhà khoa học NASA và các nhà nghiên cứu từ các trường đại học hàng đầu của Nhật Bản mới đây vừa tìm ra một số điều bất thường khi nghiên cứu các thành phần của DNA và RNA trong đá không gian, theo tờ Daily Mail.
Một số nhà khoa học tin rằng, tiểu hành tinh/thiên thạch/đá không gian đã "gieo mầm" sự sống xuống Trái đất cách đây hàng tỷ năm. Ảnh Getty/Daily Mail.
Theo Daily Mai, Trái đất của chúng ta được hình thành cách đây khoảng 4,5 tỷ năm. Trong thời kỳ đầu tồn tại, Trái đất thường xuyên bị các thiên thạch, sao chổi và các vật chất khác từ không gian đâm vào. Vào thời kỳ này, Trái đất có lẽ cũng quá nóng để có thể tồn tại sự sống cho đến khoảng 4 tỷ năm trước.
Mặc dù các hóa thạch được phát hiện sớm nhất là các mẫu vật biển có niên đại khoảng 3,5 tỷ năm trước, nhưng các nhà khoa học đã tìm ra những manh mối khiến họ cho rằng, sự sống trên Trái đất dường như được hình thành cách đây 3,8 tỷ năm.
Một số nhà khoa học cho rằng, khả năng sự sống dựa trên DNA tiến hóa sớm trên Trái đất là bởi chúng ta đã có "một bàn tay giúp đỡ" từ ngoài vũ trụ.
Những người ủng hộ giả thuyết này được gọi là "Panspermia" và họ tin rằng "sự sống" đã được "gieo mầm" xuống Trái đất nhờ các thiên thạch "du ngoạn" từ hành tinh này sang hành tinh khác, hoặc nhờ sao chổi hay bụi không gian mang đến.
Theo giả thuyết trên, sự sống trên Trái đất thực tế đã bắt nguồn từ một nơi khác trong vũ trụ và có trước cả khi Trái đất được hình thành.
Sự sống được "gieo mầm" xuống Trái đất nhờ thiên thạch có thể là sự sống sớm trên sao Hỏa, vì ngày càng nhiều nhà khoa học tin rằng, sao Hỏa có thể dễ sinh sống hơn Trái đất ở thuở sơ khai của nó.
Tuy nhiên, giả thiết sự sống được gieo mầm trên Trái đất nhờ một thiên thạch từng gặp 1 trở ngại lớn đó là, trước đây, các nhà khoa học chỉ tìm thấy hai trong bốn thành phần chính của DNA trong đá không gian. Một thành phần quan trọng - được tìm thấy trong RNA - cũng không phát hiện được trong đá không gian.
Nhưng nghiên cứu mới đây của các nhà khoa học Nhật Bản, làm việc tại trường đại học Hokkaido và Kyushu và các nhà khoa học NASA đã phát hiện ra một điều bất thường.
Trước đây, các nhà khoa học khi kiểm tra thiên thạch sẽ sử dụng axit mạnh và nhiệt để chiết xuất các thành phần DNA (được gọi là nucleobase). Tuy nhiên, nhóm nghiên cứu do nhà hóa-thiên văn học Yasuhiro Oba dẫn đầu đã sử dụng các kỹ thuật nhạy cảm hơn với thiết bị có độ phân giải siêu cao.
Theo đó, sau khi thực hiện một phân tích mới kỹ lưỡng hơn về các thiên thạch đã hạ cánh xuống Mỹ, Canada và Úc, các nhà khoa học Nhật Bản cho biết, hàng tỷ năm trước, các tảng đá không gian khổng lồ - chỉ tình cờ chứa các khối cấu tạo cơ bản của DNA - đã hạ cánh xuống Trái đất (khi đó, hoàn toàn chưa có sự sống).
Nghiên cứu của họ chỉ ra rằng, thực sự có một lượng nhỏ nucleobase trước đây chưa từng được phát hiện - được gọi là pyrimidine - trong các tảng đá không gian.
Các nhà nghiên cứu Nhật Bản kết luận rằng, pyrimidine trước đó có thể đã tránh được sự phát hiện của các nhà khoa học vì chúng có cấu trúc tinh vi hơn các nucleobase khác.
Nhóm nghiên cứu Nhật Bản đã kiểm tra vật chất từ ba thiên thạch - một thiên thạch rơi xuống Trái đất năm 1950 gần thị trấn Murray ở bang Kentucky của Mỹ, một thiên thách thứ 2 rơi xuống năm 1969 gần thị trấn Murchison ở bang Victoria của Úc, và thiên thách thứ 3 rơi xuống gần Hồ Tagish ở British Columbia của Canada.
Thiên thạch Murchison 220lb gần đây đã được xác định là có chứa vật chất lâu đời nhất trên Trái đất - đá stardust bảy tỷ năm tuổi.
Cả ba thiên thạch này đều được xếp vào nhóm đá không gian hình thành sớm trong lịch sử của Hệ mặt trời. Chúng rất giàu carbon và carbon là thành phần chính của các sinh vật trên Trái đất.
"Sự hiện diện của 5 nucleobase chính trong các thiên thạch có thể đã góp phần vào sự xuất hiện của các chức năng di truyền (DNA) trước cả khi sự sống nảy sinh trên Trái đất. Sự phong phú tuyệt đối của các nucleobase có nguồn gốc ngoài vũ trụ có thể đủ cho các phản ứng hóa học tiếp theo trên Trái đất sơ khai để hình thành nên sự sống", ông Yasuhiro Oba cho biết.
Ông Danny Glavin thuộc Trung tâm Chuyến bay Không gian Goddard của NASA và là đồng tác giả của nghiên cứu cũng nhấn mạnh rằng, nghiên cứu của họ "chắc chắn bổ sung vào danh sách các hợp chất hóa học có mặt trên Trái đất trước khi sự sống xuất hiện".
Một số nhà khoa học khác cũng tỏ ra phấn kích với phát hiện trên.
"Đây là một trong những thành phần cuối cùng trong danh sách mà chúng tôi cần chứng minh rằng chúng đã được tạo ra trong không gian", Giáo sư Mark Sephton, một nhà thiên văn học tại Đại học Hoàng gia London bình luận.
"Chúng tôi rất may mắn khi đã có những mẫu vật rất lâu đời này - những mẫu vật đưa chúng tôi đến một cánh cửa mở ra những điều kiện và sự kiện hàng tỷ năm về trước", ông Sephton nói thêm.
Theo Daily Mail, nghiên cứu mới trên chắc chắn củng cố phần nào giả thuyết rằng, sự sống trên Trái đất có thể đến từ tiểu hành tinh ngoài vũ trụ.
Những người ủng hộ giả thiết này đang hy vọng rằng, họ sẽ có bằng chứng vững chắc hơn khi có thể kiểm tra các mẫu lấy từ hai tiểu hành tinh lớn - Ryugu và Bennu - bằng tàu vũ trụ được phát triển bởi NASA và Cơ quan không gian của Nhật Bản, JAXA.
Cơ quan Hàng không Vũ trụ Mỹ (NASA) mới chia sẻ một video mô phỏng sự xuất hiện của lỗ đen - một khái niệm mà dù chúng ta có đọc hết vài cuốn sách cũng chưa chắc hình dung...
Nguồn: [Link nguồn]